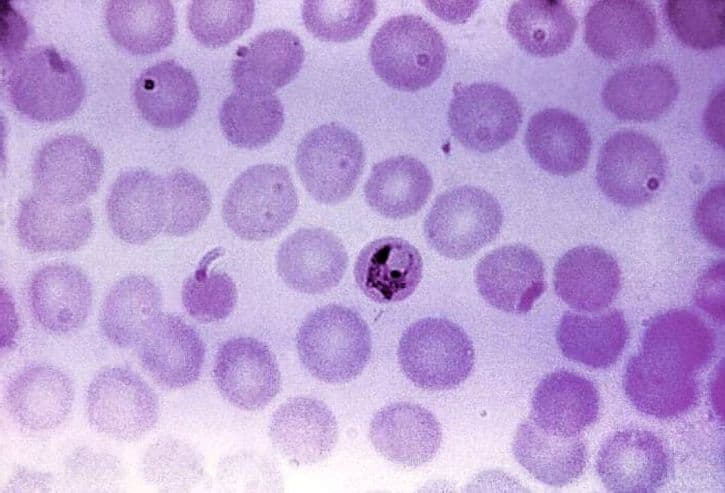
넥스가드 스펙트라 4

넥스가드 스펙트라
강아지를 키우고 계신 분들께서는 반려견의 건강을 항시 신경쓰고 살아가고 계시리라 생각이 드는데요.
강아지를 키우고 계신 분들께서는 반려견의 건강을 항시 신경쓰고 살아가고 계시리라 생각이 드는데요.
1주요 내용
저의 경우에도 반려견과 함께 한 세월이 꽤 길다보니 더욱 애정을 가지고 케어를 해주고 있어요. 혹시나 아프지는 않을까 걱정이 많기도 한데 이러한 걱정을 조금이라도 덜고 반려견의 건강을 챙기기 위해서 좋은 제품을 알아보고 복용시키고 있어요. 그 중에서도 반려견에게 치명적이라고 할 수 있는 심장사상충과 진드기에 대한 문제를 방지하기 위해서 매달 한번씩 구충제를 먹이고 있기는 한데요. 요즘 날이 더워지면서 산책을 할때마다 현재 내가 사용하고 있는 제품이 가장 좋은 제품이 맞는 것일까하는 우려가 생기게 되더라고요. 심장사상충은 모기로부터 감염

2상세 설명
이 되는 것이고 꽤나 무서운 질병이고 진드기또한 산책을 할때 주의해야해서 모기와 진드기가 많아지는 요즘과 같은 날씨가 오게 되면 걱정이 될 수 밖에 없는 듯 해요. 그래서 이번에 검색을 해서 넥스가드 스펙트라에 대해서 알아보게 되었는데 주변에서도 그렇고 여러 사람들이 넥스가드 스펙트라를 추천하고 있길래 궁금한 마음에 직접 정보를 알아보기로 한 것이죠. 지금부터 넥스가드 스펙트라에 대한 정보를 알려드릴테니 반려견을 키우고 계신 분들도 도움 받으셨으면 해요. 일단 넥스가드 스펙트라의 복용방법의 경우에는 매달 1정을 체주에 맞게 먹이면 되는
3활용 방법
방식인데요. 총 다섯종류로 이루어져있는데 엑스스몰의 경우에는 2킬로그램에서 3.5킬로그램의 강아지들이 먹어야하고 스몰 사이즈는 3.5킬로그램에서 7.5킬로그램의 강아지가 먹어야하며 미디움 사이즈는 7.5킬로그램에서 15킬로그램의 강이지에게 먹이며 라지 사이즈는 15킬로그램에서 30킬로그램 강아지들에게, 마지막으로 엑스라지 사이즈는 30킬로그램에서 60킬로그램의 몸무게를 가진 강아지들에게 급여를 하면 된다고 나와있어요. 이렇게 나누어진 넥스가드 스펙트라 종류는 각각 색상이 다르게 구성되어 있어서 약국에서도 원하는 종류를 바로바로 구분해

4추가 정보
낼 수 있을 것 같은데 엑스스몰은 주황색, 스몰은 노란색, 미디움은 초록색, 라지는 보라색, 엑스라지는 빨간색으로 표시되어 있어요. 이러한 넥스가드 스펙트라의 경우에는 동물약국, 동물병원에 가면 쉽게 보실 수 있는데 저희 강아지의 경우에는 4킬로그램의 몸무게를 가지고 있어서 스몰사이즈를 선택하면 될 것 같았고 대충 시세를 보니 2개를 구매하면 11만원이 약간 넘는 금액임을 알 수 있었어요. 물론 약국, 병원마다 차이는 있겠지만 이렇게 구매를 하게 되면 총 6개월치이니 한달에 19000원 정도를 사용한다고 보실 수 있고 그렇게 부담되지 않

5심화 내용
는 가격이라서 많은 사람들이 이용하고 있는듯 했네요. 하지만 요즘 넥스가드 스펙트라를 이용하는 사람들이 많아지고 찾는 사람들도 많아지다보니 약국이나 병원에 재고가 없는 경우도 있다고 하니 미리 전화를 해서 문의를 해보고 진열되어 있다면 쟁여두시는 것도 좋을 것 같다는 생각이 들었네요. 넥스가드 스펙트라를 먹이려하실때는 식사와는 상관없이 어느때나 먹이시면 되고 한달에 한번 체중에 맞게 먹이되 8주령 이상의 강아지부터 복용이 된다고 하니 참고하시어 구매하시면 될 듯 하네요. 이번에는 넥스가드 스펙트라의 구충범위를 알아보았는데 아무래도 한가

6참고 사항
지 제품만 이용하면서도 여러 구충들을 잡아낼 수 있다면 더욱 효과적이라는 생각이 들 수 밖에 없는 것 같아서 알아보게 되었어요. 제가 현재 이용하고 있는 구충제의 경우에는 구충범위가 넓지 못해서 산책을 나갈때에도 반려견이 수풀쪽으로 들어가려고하면 걱정부터 되더라고요. 그런데 넥스가드 스펙트라의 경우에는 심장사상충과 함께 벼룩과 회충, 참진드기와 편충, 구충과 모낭충, 귀진드기와 몸진드기까지 케어가 가능하다고 해요. 그래서 이를 한번에 해결할 수 있는 구충제라 올인원 구충제라고도 불리운다고 하는데요. 이외에도 넥스가드 스펙트라만이 가지

77번째 정보
고 있는 특장점은 더 있는데, 그 중에서 안전함을 먼저 말씀드릴 수 있어요. 반려견에 대한 애정이 큰지라 이러한 제품을 먹이려할때 가장 우선적으로 보게 되는 것이 안전성이였는데 넥스가드 스펙트라는 이미 유럽 각지와 일본에서 널리 판매가 되고 있는 제품이라서 안정성 및 효능이 확인이 되어있는 구충제라고 보시면 돼요. 그리고 무엇보다도 맛있어서 강아지가 좋아한다고 하는데 소고기맛을 가지고있어서 반려견에도 큰 거부감없이 먹일 수 있으며 기존에 여러 제품들이 가지고 있었던 것처럼 바르는 형태가 아니라 먹이는 형태라서 피부 부작용에 대한 걱정을

88번째 정보
하지 않을 수 있으며 더불어 알약 형태가 아닌 츄어블 형태라서 간식 느낌으로 어렵지않게 먹일 수 있다는 장점을 가지고 있어요. 그래서 넥스가드 스펙트라에서는 이러한 보호자분들에게 제품을 강력하게 추천한다고 하는데요. 한개의 구충제 제품으로 심장사상충은 물론이며 외부 기생충들까지 한꺼번에 해결하고픈 분들, 피부 부작용이나 털빠짐으로 인해서 바르는 구충제를 사용하기 꺼려지는 분들, 맛있게 먹일 수 있는 구충제를 찾고 계신 분들, 어린 강아지에게도 안전한 구충제를 투여하고 싶은 분들께 추천한다고 해요. 저의 경우에는 첫번째에 해당이 되는 사
99번째 정보
람이라서 이번에 넥스가드 스펙트라를 구매해보려고 하는데요. 여러분들께서도 위의 내용을 잘 읽어보시고 해당이 되신다면 이번 기회에 넥스가드 스펙트라 구매해서 반려견에게 복용시키는 것은 어떠실까 싶네요. 그리고 현재 카카오톡 플러스 친구로 넥스가드 스펙트라를 추가하게 되면 넥스가드 스펙트라 투약일에 맞춰서 알림서비스를 받을 수 있다고 해요. 저 또한 구충제 투약일을 매달 기억하는 것이 힘들기도 했었는데 넥스가드 스펙트라 카카오톡 플러스 친구 등록시 알림서비스가 제공되니 앞으로는 넥스가드 스펙트라 투약일 잊을 일 전혀 없을 것 같아요.
💡 추가 꿀팁
- 정확한 정보는 전문가와 상담하세요
- 더 자세한 내용은 관련 기관에 문의하시기 바랍니다